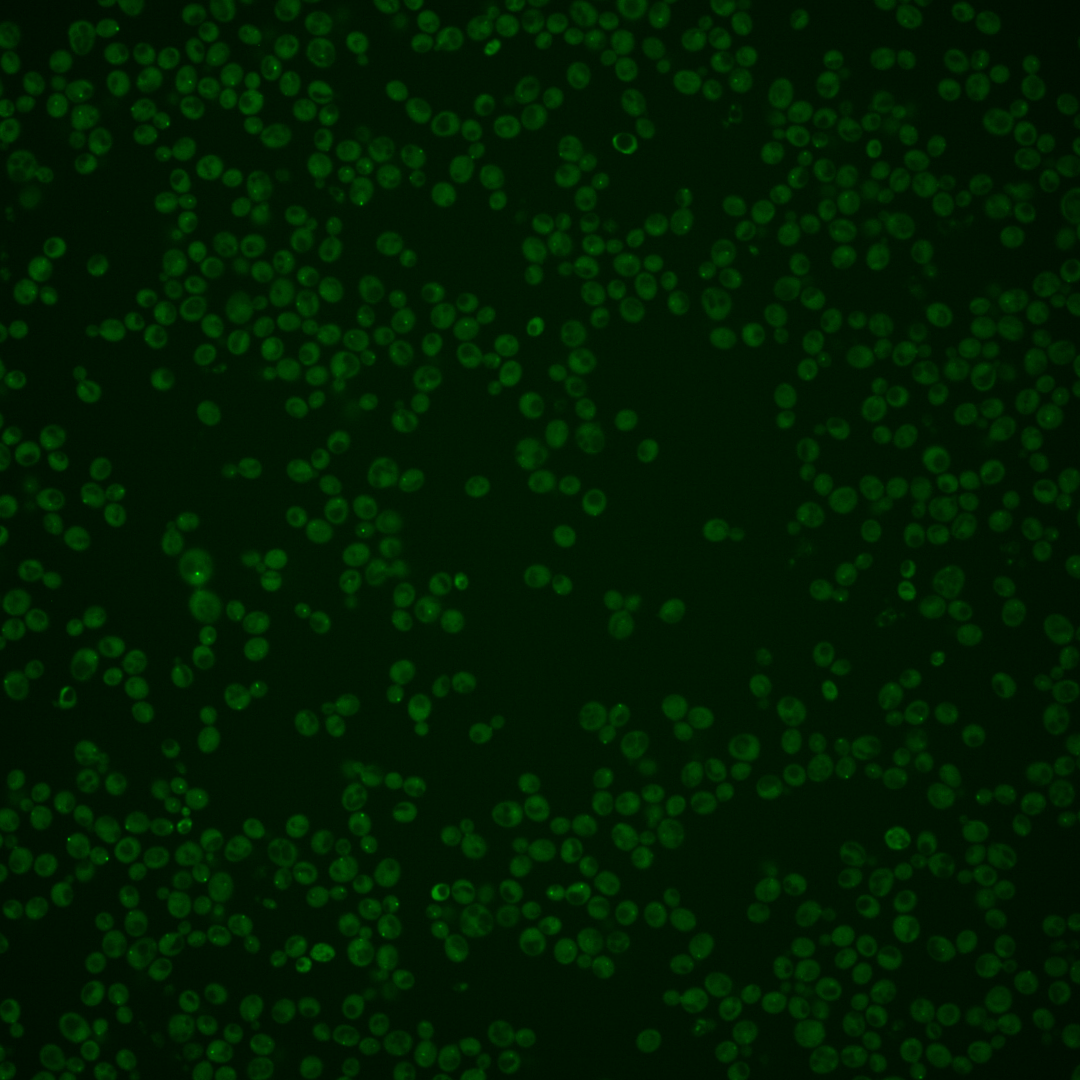
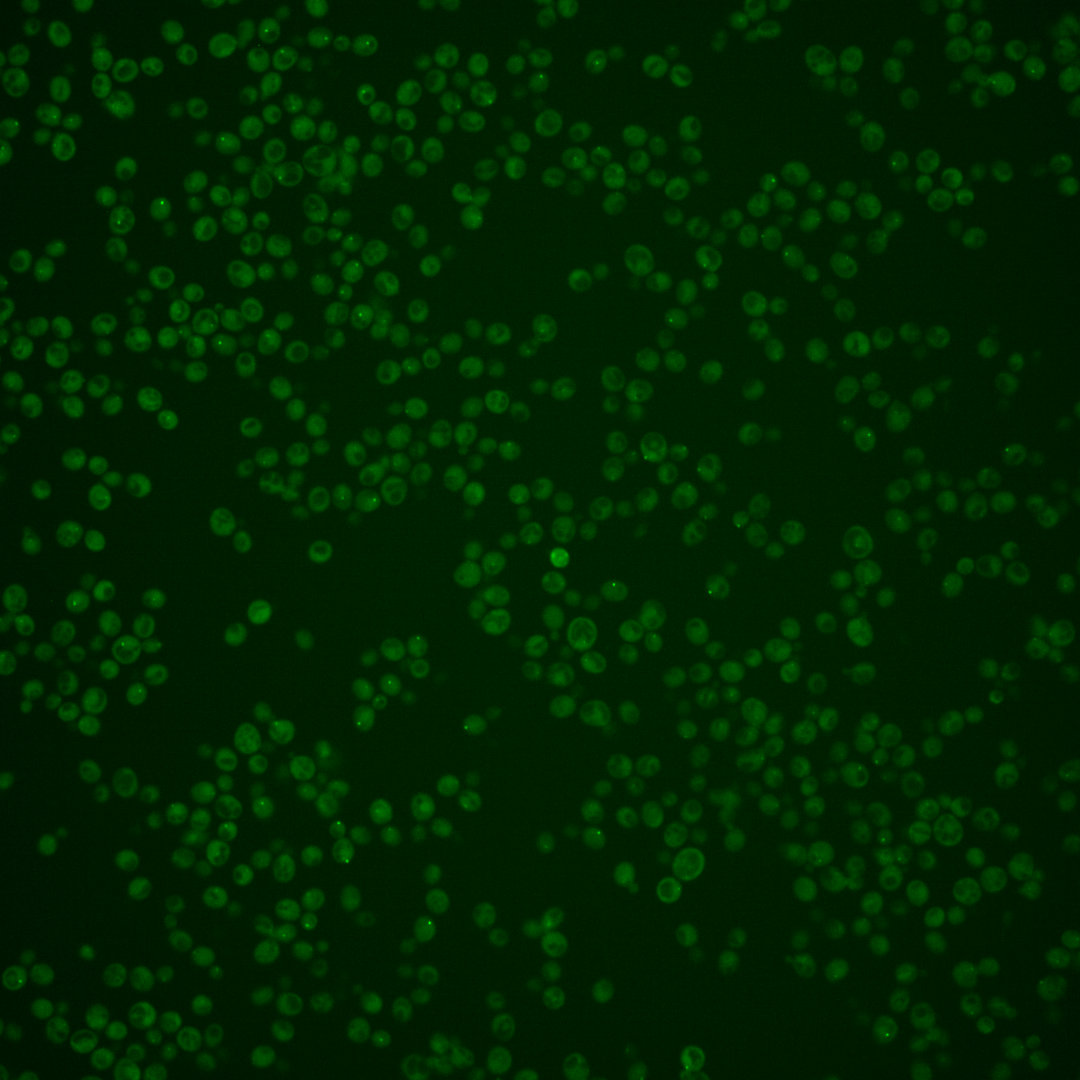
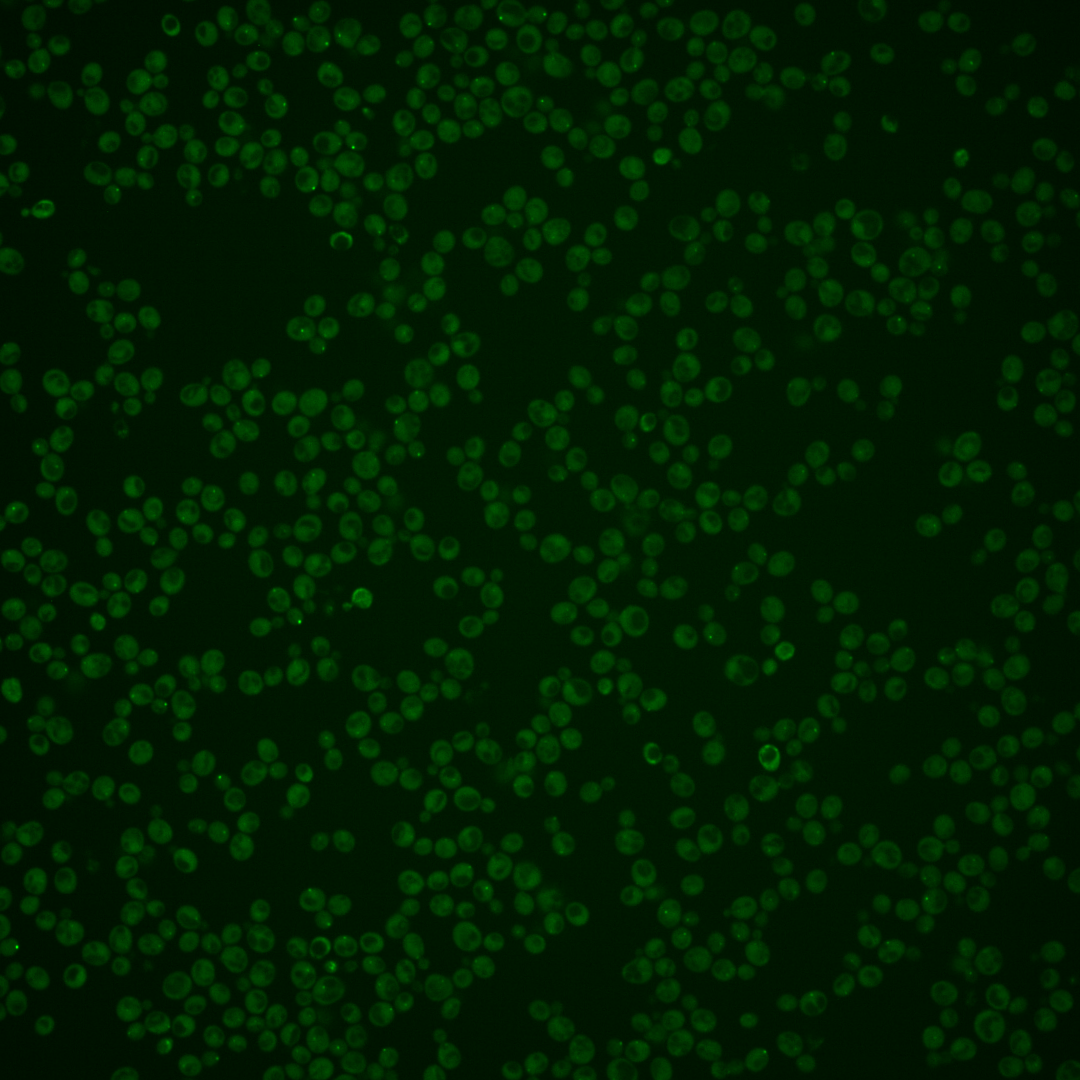
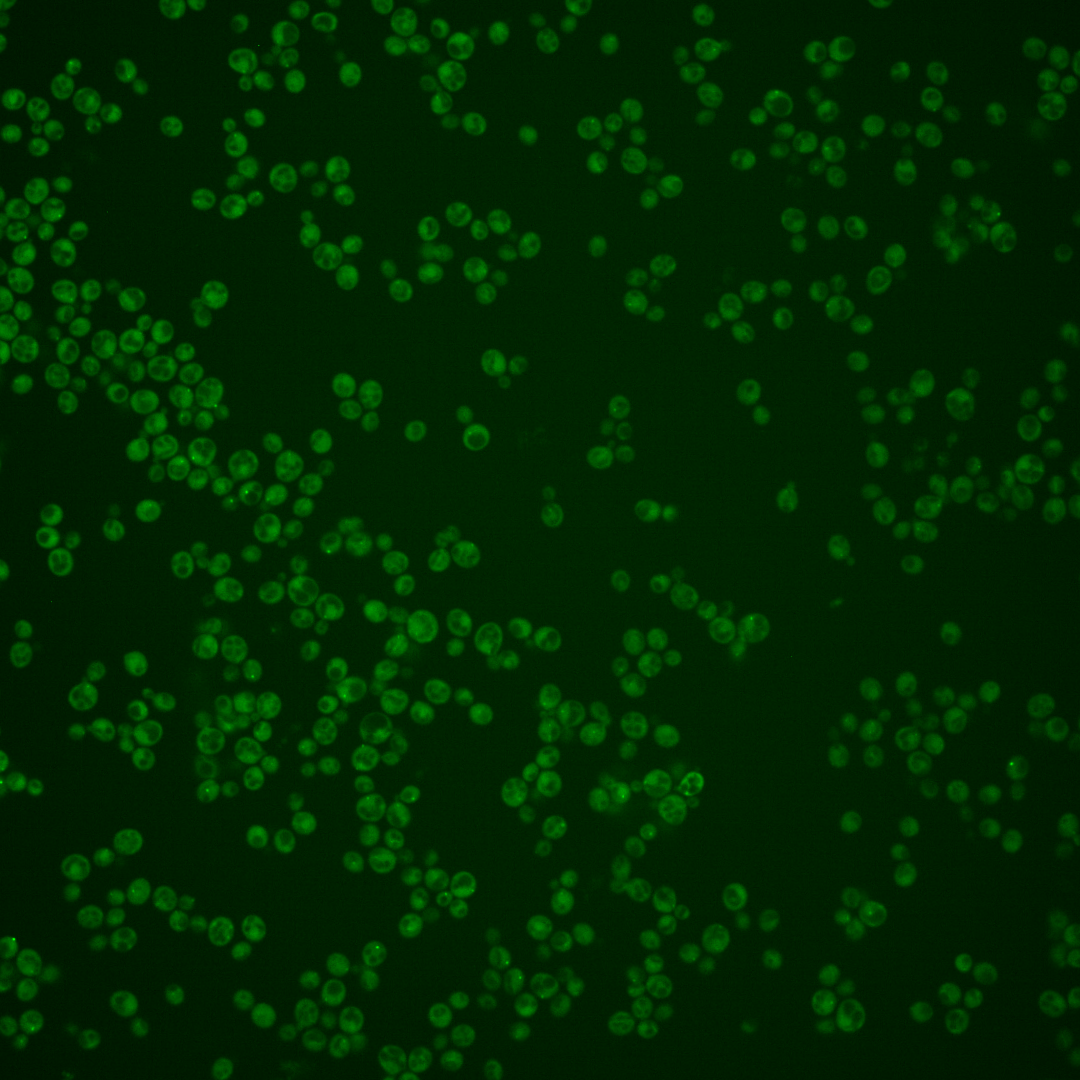
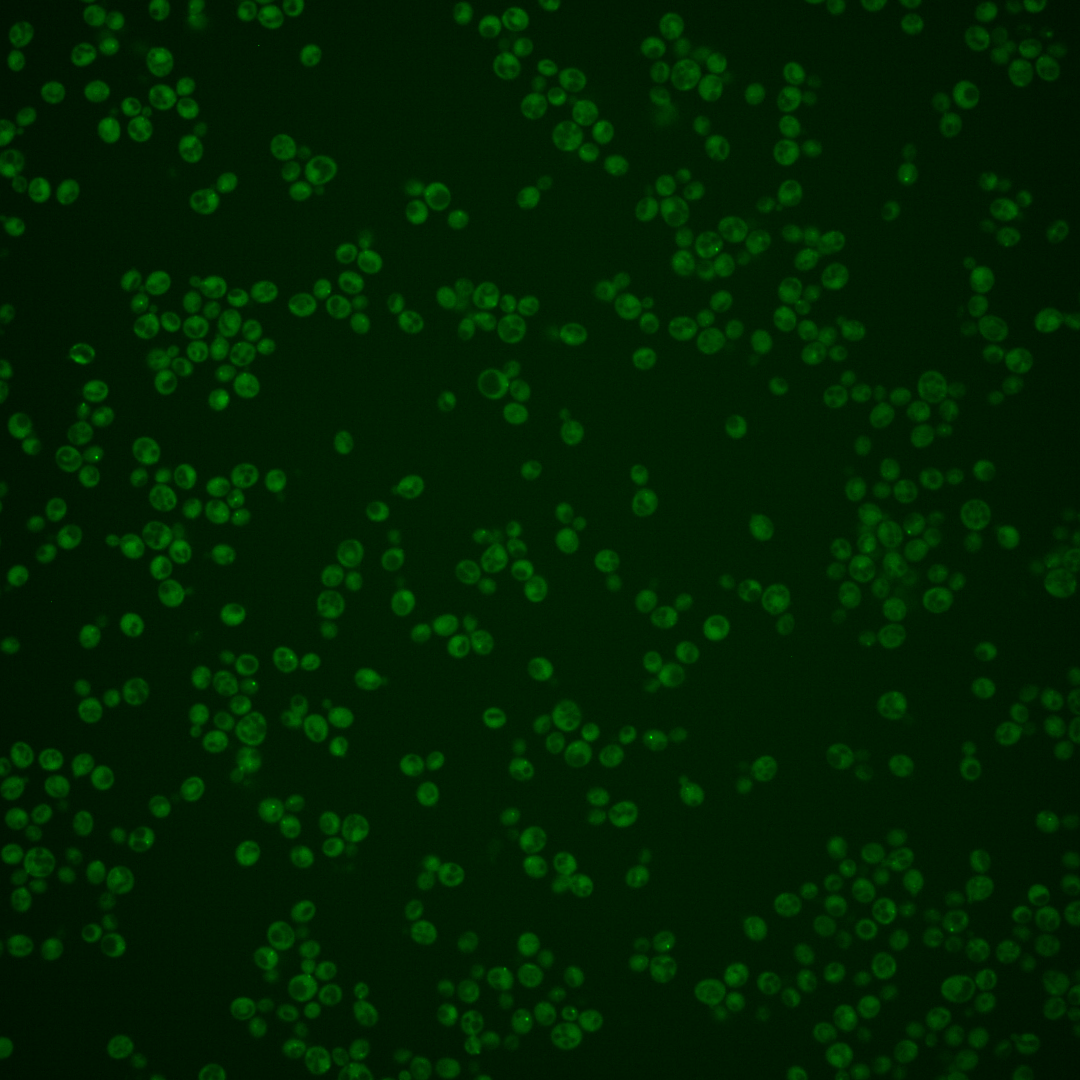
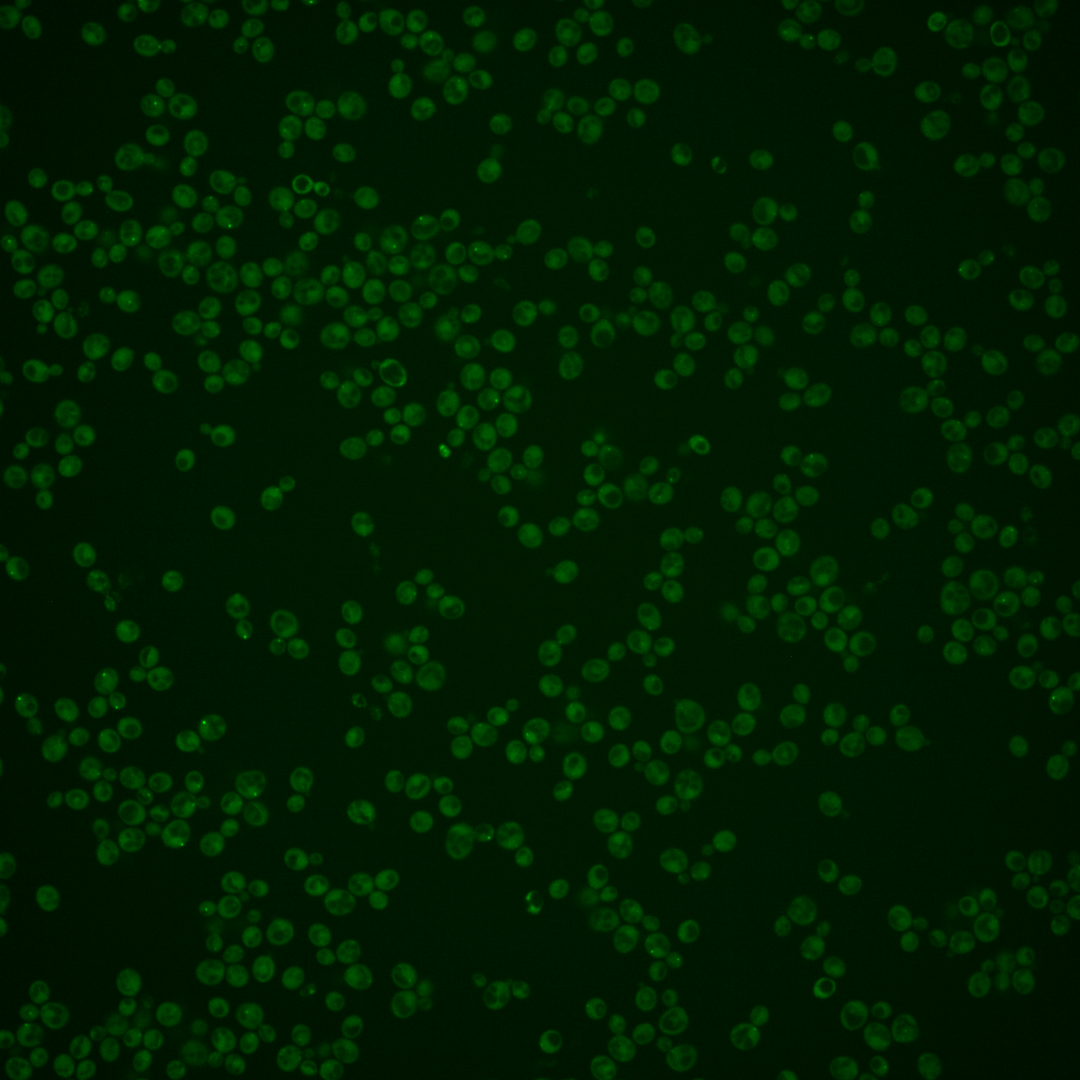

| Standard name | |
|---|---|
| Human Ortholog | |
| Description | Protein kinase of the Mitotic Exit Network; localized to the spindle pole bodies at late anaphase; promotes mitotic exit by directly switching on the kinase activity of Dbf2p; required for spindle disassembly after meiosis II; relocalizes to the cytoplasm upon DNA replication stress |
Micrographs




















































































Sub-cellular Localization
Yeast GFP Assignment
Protein Abundance
Localization Change
External localization resources
| ensLOC | DeepLoc | |||||||||||||||||||||||
|---|---|---|---|---|---|---|---|---|---|---|---|---|---|---|---|---|---|---|---|---|---|---|---|---|
| Localization | WT1 | WT2 | WT3 | RAP60 | RAP140 | RAP220 | RAP300 | RAP380 | RAP460 | RAP540 | RAP620 | RAP700 | HU80 | HU120 | HU160 | rpd3Δ_1 | rpd3Δ_2 | rpd3Δ_3 | WT1 | WT2 | WT3 | AF100 | AF140 | AF180 |
| Cortical Patches | 5 | 4 | 3 | 3 | 1 | 4 | 1 | 3 | 1 | 0 | 5 | 0 | 1 | 4 | 1 | 1 | 3 | 3 | 5 | 7 | 7 | 2 | 1 | 3 |
| Bud | 2 | 7 | 19 | 17 | 18 | 27 | 21 | 25 | 21 | 30 | 14 | 30 | 3 | 1 | 9 | 1 | 2 | 2 | 1 | 1 | 2 | 1 | 1 | 2 |
| Bud Neck | 1 | 0 | 11 | 5 | 6 | 11 | 8 | 4 | 5 | 6 | 3 | 1 | 0 | 0 | 0 | 1 | 1 | 0 | 2 | 5 | 3 | 2 | 0 | 1 |
| Bud Site | 1 | 0 | 0 | 4 | 2 | 2 | 4 | 8 | 10 | 6 | 5 | 6 | 0 | 0 | 0 | 0 | 1 | 0 | – | – | – | – | – | – |
| Cell Periphery | 0 | 1 | 2 | 1 | 2 | 2 | 0 | 2 | 1 | 0 | 5 | 5 | 0 | 1 | 1 | 0 | 3 | 2 | 0 | 0 | 1 | 0 | 0 | 0 |
| Cytoplasm | 102 | 180 | 140 | 139 | 151 | 227 | 161 | 234 | 162 | 206 | 110 | 152 | 151 | 170 | 180 | 16 | 10 | 35 | 87 | 166 | 100 | 114 | 149 | 158 |
| Endoplasmic Reticulum | 5 | 8 | 1 | 1 | 1 | 3 | 0 | 1 | 0 | 1 | 3 | 0 | 0 | 3 | 1 | 4 | 1 | 4 | 2 | 2 | 1 | 0 | 0 | 3 |
| Endosome | 6 | 23 | 0 | 0 | 12 | 13 | 9 | 5 | 5 | 0 | 2 | 2 | 16 | 11 | 7 | 8 | 2 | 10 | 12 | 22 | 9 | 1 | 1 | 2 |
| Golgi | 0 | 0 | 0 | 0 | 0 | 0 | 0 | 0 | 0 | 0 | 0 | 0 | 0 | 0 | 0 | 0 | 0 | 1 | 1 | 1 | 0 | 0 | 0 | 2 |
| Mitochondria | 0 | 20 | 13 | 39 | 13 | 91 | 74 | 131 | 123 | 143 | 101 | 145 | 0 | 0 | 10 | 4 | 1 | 3 | 7 | 18 | 36 | 4 | 4 | 3 |
| Nucleus | 0 | 1 | 0 | 0 | 0 | 1 | 1 | 3 | 2 | 2 | 5 | 0 | 1 | 0 | 0 | 0 | 0 | 0 | 0 | 0 | 0 | 0 | 0 | 0 |
| Nuclear Periphery | 0 | 0 | 0 | 0 | 0 | 0 | 1 | 1 | 0 | 0 | 0 | 0 | 0 | 0 | 0 | 0 | 0 | 0 | 0 | 1 | 0 | 0 | 0 | 0 |
| Nucleolus | 1 | 0 | 0 | 0 | 1 | 0 | 1 | 1 | 1 | 0 | 2 | 0 | 0 | 0 | 0 | 1 | 0 | 0 | 0 | 0 | 0 | 0 | 0 | 0 |
| Peroxisomes | 0 | 7 | 0 | 0 | 2 | 5 | 3 | 1 | 5 | 2 | 6 | 5 | 1 | 1 | 0 | 0 | 0 | 0 | 0 | 0 | 0 | 0 | 0 | 0 |
| SpindlePole | 26 | 19 | 26 | 31 | 27 | 57 | 34 | 48 | 37 | 35 | 32 | 40 | 5 | 2 | 1 | 8 | 11 | 21 | 37 | 40 | 57 | 4 | 0 | 0 |
| Vac/Vac Membrane | 0 | 0 | 0 | 0 | 0 | 0 | 1 | 3 | 2 | 0 | 1 | 3 | 0 | 0 | 1 | 3 | 1 | 0 | 1 | 3 | 13 | 3 | 3 | 5 |
| Unique Cell Count | 138 | 242 | 185 | 197 | 205 | 361 | 272 | 375 | 283 | 335 | 223 | 299 | 170 | 187 | 201 | 35 | 27 | 62 | 161 | 279 | 240 | 137 | 169 | 189 |
| Labelled Cell Count | 149 | 270 | 215 | 240 | 236 | 443 | 319 | 470 | 375 | 431 | 294 | 389 | 178 | 193 | 211 | 47 | 36 | 81 | 161 | 279 | 240 | 137 | 169 | 189 |
Yeast GFP Assignment
Protein Abundance
| Screen | WT1 | WT2 | WT3 | RAP60 | RAP140 | RAP220 | RAP300 | RAP380 | RAP460 | RAP540 | RAP620 | RAP700 | HU80 | HU120 | HU160 | rpd3Δ_1 | rpd3Δ_2 | rpd3Δ_3 | AF100 | AF140 | AF180 |
|---|---|---|---|---|---|---|---|---|---|---|---|---|---|---|---|---|---|---|---|---|---|
| Mean Cell GFP Intensity (1e-4) | 5.6 | 4.5 | 5.4 | 3.6 | 4.1 | 3.6 | 3.9 | 3.6 | 3.1 | 3.1 | 3.3 | 2.9 | 5.0 | 5.2 | 4.6 | 6.4 | 6.8 | 7.5 | 5.0 | 5.2 | 6.0 |
| Std Deviation (1e-4) | 0.6 | 1.0 | 5.6 | 0.9 | 1.6 | 1.1 | 2.3 | 1.1 | 1.1 | 1.1 | 1.6 | 0.7 | 0.9 | 1.4 | 1.2 | 1.2 | 0.7 | 2.0 | 1.2 | 1.3 | 1.6 |
| Intensity Change (Log2) | – | – | – | -0.61 | -0.4 | -0.59 | -0.48 | -0.59 | -0.8 | -0.83 | -0.7 | -0.92 | -0.11 | -0.06 | -0.24 | 0.25 | 0.33 | 0.46 | -0.11 | -0.06 | 0.14 |
Localization Change
| Localization | RAP60 | RAP140 | RAP220 | RAP300 | RAP380 | RAP460 | RAP540 | RAP620 | RAP700 | HU80 | HU120 | HU160 | rpd3Δ_1 | rpd3Δ_2 | rpd3Δ_3 |
|---|---|---|---|---|---|---|---|---|---|---|---|---|---|---|---|
| Actin | – | – | – | – | – | – | – | – | – | – | – | – | – | – | – |
| Bud | – | – | – | – | – | – | – | – | – | – | – | – | – | – | – |
| Bud Neck | – | – | – | – | – | – | – | – | – | – | – | – | – | – | – |
| Bud Site | – | – | – | – | – | – | – | – | – | – | – | – | – | – | – |
| Cell Periphery | – | – | – | – | – | – | – | – | – | – | – | – | – | – | – |
| Cyto | – | – | – | – | – | – | – | – | – | – | – | – | – | – | – |
| Endoplasmic Reticulum | – | – | – | – | – | – | – | – | – | – | – | – | – | – | – |
| Endosome | – | – | – | – | – | – | – | – | – | – | – | – | – | – | – |
| Golgi | – | – | – | – | – | – | – | – | – | – | – | – | – | – | – |
| Mitochondria | – | – | – | – | – | – | – | – | – | – | – | – | – | – | – |
| Nuclear Periphery | – | – | – | – | – | – | – | – | – | – | – | – | – | – | – |
| Nuc | – | – | – | – | – | – | – | – | – | – | – | – | – | – | – |
| Nucleolus | – | – | – | – | – | – | – | – | – | – | – | – | – | – | – |
| Peroxisomes | – | – | – | – | – | – | – | – | – | – | – | – | – | – | – |
| SpindlePole | – | – | – | – | – | – | – | – | – | – | – | – | – | – | – |
| Vac | – | – | – | – | – | – | – | – | – | – | – | – | – | – | – |
| Cortical Patches | – | – | – | – | – | – | – | – | – | – | – | – | – | – | – |
| Cytoplasm | – | – | – | – | – | – | – | – | – | – | – | – | – | – | – |
| Nucleus | – | – | – | – | – | – | – | – | – | – | – | – | – | – | – |
| Vacuole | – | – | – | – | – | – | – | – | – | – | – | – | – | – | – |
External localization resources
Images






























Protein Concentration and Protein Localization Data
| R1 | R2 | R3 | ||||||||||||||||
|---|---|---|---|---|---|---|---|---|---|---|---|---|---|---|---|---|---|---|
| G1 Pre-START | G1 Post-START | S/G2 | Metaphase | Anaphase | Telophase | G1 Pre-START | G1 Post-START | S/G2 | Metaphase | Anaphase | Telophase | G1 Pre-START | G1 Post-START | S/G2 | Metaphase | Anaphase | Telophase | |
| Concentration | 1.6475 | 1.5231 | 1.2555 | 1.0154 | 1.2037 | 1.3745 | 1.9578 | 2.4268 | 2.3248 | 2.3745 | 2.2888 | 2.2438 | 2.8053 | 3.9317 | 3.1538 | 2.3278 | 2.6279 | 3.2525 |
| Actin | 0.076 | 0.0131 | 0.0166 | 0.0183 | 0.0267 | 0.0067 | 0.0111 | 0.0023 | 0.0105 | 0.0205 | 0.0073 | 0.0065 | 0.0063 | 0.0163 | 0.0058 | 0.009 | 0.0029 | 0.006 |
| Bud | 0.0017 | 0.0023 | 0.002 | 0.0017 | 0.0007 | 0.0003 | 0.0004 | 0.003 | 0.0023 | 0.0006 | 0.0015 | 0.0001 | 0.0007 | 0.0003 | 0.0002 | 0.0005 | 0.0005 | 0.0001 |
| Bud Neck | 0.0016 | 0.0025 | 0.0038 | 0.0159 | 0.0044 | 0.0055 | 0.003 | 0.0003 | 0.001 | 0.0226 | 0.0009 | 0.0009 | 0.0007 | 0.0003 | 0.0019 | 0.0351 | 0.0004 | 0.0016 |
| Bud Periphery | 0.0035 | 0.0008 | 0.0028 | 0.0011 | 0.0012 | 0.0006 | 0.0006 | 0.0083 | 0.0067 | 0.0019 | 0.0044 | 0.0001 | 0.0023 | 0.0003 | 0.0003 | 0.0004 | 0.0005 | 0.0001 |
| Bud Site | 0.0058 | 0.0149 | 0.0125 | 0.007 | 0.004 | 0.0008 | 0.0061 | 0.0053 | 0.0094 | 0.0022 | 0.003 | 0.0004 | 0.0014 | 0.0027 | 0.0009 | 0.0021 | 0.0006 | 0.0002 |
| Cell Periphery | 0.0012 | 0.0008 | 0.0005 | 0.0004 | 0.0003 | 0.0002 | 0.0006 | 0.0003 | 0.0003 | 0.0015 | 0.0003 | 0.0001 | 0.0012 | 0.0006 | 0.0002 | 0.0001 | 0.0001 | 0.0001 |
| Cytoplasm | 0.3555 | 0.4785 | 0.4667 | 0.5246 | 0.1028 | 0.3786 | 0.3128 | 0.4481 | 0.3029 | 0.3714 | 0.1733 | 0.3779 | 0.3549 | 0.4349 | 0.3851 | 0.3703 | 0.07 | 0.3065 |
| Cytoplasmic Foci | 0.0964 | 0.1442 | 0.1359 | 0.0811 | 0.4912 | 0.247 | 0.1641 | 0.119 | 0.1711 | 0.0584 | 0.2601 | 0.2331 | 0.2757 | 0.1511 | 0.1738 | 0.2553 | 0.5389 | 0.2578 |
| Eisosomes | 0.0006 | 0.0006 | 0.0002 | 0.0004 | 0.0003 | 0.0001 | 0.0005 | 0.0001 | 0.0003 | 0.0003 | 0.0002 | 0 | 0.0002 | 0.0002 | 0.0002 | 0.0001 | 0.0001 | 0.0001 |
| Endoplasmic Reticulum | 0.0139 | 0.0049 | 0.0108 | 0.007 | 0.0019 | 0.0049 | 0.0058 | 0.0021 | 0.003 | 0.009 | 0.0053 | 0.0022 | 0.0098 | 0.0092 | 0.009 | 0.006 | 0.0045 | 0.0037 |
| Endosome | 0.047 | 0.0128 | 0.0423 | 0.0587 | 0.0759 | 0.0428 | 0.0524 | 0.0146 | 0.0385 | 0.0299 | 0.117 | 0.032 | 0.0293 | 0.0654 | 0.0421 | 0.0426 | 0.0636 | 0.0323 |
| Golgi | 0.0143 | 0.002 | 0.0041 | 0.0085 | 0.0182 | 0.0037 | 0.0096 | 0.001 | 0.0114 | 0.0037 | 0.0114 | 0.0032 | 0.0032 | 0.0039 | 0.0032 | 0.0071 | 0.0085 | 0.0029 |
| Lipid Particles | 0.02 | 0.0042 | 0.0097 | 0.0158 | 0.0901 | 0.0068 | 0.0313 | 0.0008 | 0.009 | 0.0089 | 0.0254 | 0.0028 | 0.0078 | 0.0146 | 0.0047 | 0.0035 | 0.0175 | 0.0138 |
| Mitochondria | 0.0104 | 0.0025 | 0.0031 | 0.0293 | 0.0053 | 0.0032 | 0.0049 | 0.0012 | 0.0068 | 0.0019 | 0.0622 | 0.0006 | 0.0006 | 0.0003 | 0.0007 | 0.0012 | 0.0011 | 0.0006 |
| None | 0.2869 | 0.2977 | 0.2495 | 0.192 | 0.1331 | 0.188 | 0.3264 | 0.3754 | 0.3918 | 0.4397 | 0.2718 | 0.253 | 0.2755 | 0.288 | 0.3557 | 0.1038 | 0.1334 | 0.2611 |
| Nuclear Periphery | 0.0147 | 0.0009 | 0.0067 | 0.0019 | 0.0018 | 0.0012 | 0.0107 | 0.0004 | 0.0016 | 0.0085 | 0.0072 | 0.0005 | 0.0025 | 0.0019 | 0.0013 | 0.0521 | 0.0428 | 0.0008 |
| Nucleolus | 0.0006 | 0.0003 | 0.0012 | 0.0021 | 0.0007 | 0.0004 | 0.0066 | 0.0002 | 0.0003 | 0.0005 | 0.0012 | 0.0001 | 0.0007 | 0.0002 | 0.0002 | 0.0008 | 0.0013 | 0.0004 |
| Nucleus | 0.0163 | 0.0013 | 0.0055 | 0.002 | 0.0011 | 0.0013 | 0.007 | 0.0009 | 0.0012 | 0.0039 | 0.0079 | 0.0007 | 0.0028 | 0.0011 | 0.0011 | 0.0689 | 0.0274 | 0.001 |
| Peroxisomes | 0.0105 | 0.0027 | 0.0078 | 0.0091 | 0.0313 | 0.0044 | 0.0226 | 0.0028 | 0.0182 | 0.002 | 0.0193 | 0.0083 | 0.0099 | 0.0019 | 0.0086 | 0.0159 | 0.0557 | 0.014 |
| Punctate Nuclear | 0.0167 | 0.0108 | 0.011 | 0.0019 | 0.006 | 0.0995 | 0.0172 | 0.0122 | 0.0091 | 0.0086 | 0.0083 | 0.0766 | 0.0125 | 0.0022 | 0.0035 | 0.0239 | 0.0281 | 0.0953 |
| Vacuole | 0.0045 | 0.0018 | 0.0062 | 0.0189 | 0.002 | 0.003 | 0.0051 | 0.0014 | 0.0038 | 0.0033 | 0.0088 | 0.0009 | 0.0018 | 0.0042 | 0.0016 | 0.0008 | 0.0016 | 0.0013 |
| Vacuole Periphery | 0.0016 | 0.0002 | 0.0011 | 0.0024 | 0.0007 | 0.0009 | 0.0012 | 0.0002 | 0.001 | 0.0007 | 0.0033 | 0.0002 | 0.0003 | 0.0004 | 0.0002 | 0.0006 | 0.0006 | 0.0003 |
Sequencing Data
| R1 | R2 | |||||||||
|---|---|---|---|---|---|---|---|---|---|---|
| G1 Post-START | S/G2 | Metaphase | Anaphase | Telophase | G1 Post-START | S/G2 | Metaphase | Anaphase | Telophase | |
| Gene Expression | 6.6016 | 6.07 | 5.7554 | 7.4391 | 4.891 | 6.4094 | 8.5241 | 8.7449 | 6.8471 | 8.3832 |
| Translational Efficiency | 0.529 | 0.451 | 0.4032 | 0.2901 | 0.5795 | 0.5779 | 0.3958 | 0.3308 | 0.4755 | 0.4456 |
Hit Data
| Dataset | Hit |
|---|---|
| Protein Concentration | ✘ |
| Protein Localization | ✘ |
| Gene Expression | ✘ |
| Translational Efficiency | ✘ |
Endocytosis
| Temp | Actin Patch (Sac6-tdTomato) | Cortical Patch (Sla1-GFP) | Late Endosome (Snf7-GFP) | Vacuole (Vph1-GFP) |
|---|---|---|---|---|
| 37℃ | ||||
| RT |
Cell Cycle Omics
CYCLoPs (Cdc15-GFP)
| Gene / Allele | Actin Patch (Sac6-tdTomato) | Cortical Patch (Sla1-GFP) | Late Endosome (Snf7-GFP) | Vacuole (Sac6-tdTomato) |
|---|
| Gene | Images |
|---|
| Gene | Images |
|---|
Images are not yet available
Images are not yet available